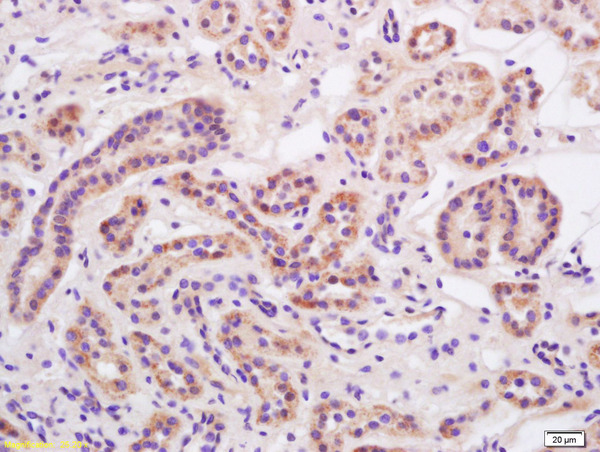
Formalin-fixed and paraffin embedded rat kidney labeled with Anti-Alpha-ENaC Polyclonal Antibody, Unconjugated (bs-2957R) at 1:200 followed by conjugation to the secondary antibody and DAB staining.

Paraformaldehyde-fixed, paraffin embedded human kidney; Antigen retrieval by boiling in sodium citrate buffer (pH6) for 15min; Block endogenous peroxidase by 3% hydrogen peroxide for 30 minutes; Blocking buffer (normal goat serum) at 37°C for 20min; Antibody incubation with Alpha-ENaC Polyclonal Antibody, Unconjugated (bs-2957R) at 1:200 overnight at 4°C, followed by a conjugated secondary and DAB staining.
SCNN1A Polyclonal Antibody
BS-2957R
ApplicationsFlow Cytometry, ImmunoFluorescence, Western Blot, ELISA, ImmunoCytoChemistry, ImmunoHistoChemistry, ImmunoHistoChemistry Frozen, ImmunoHistoChemistry Paraffin
Product group Antibodies
ReactivityHuman, Mouse, Rat
TargetSCNN1A
Overview
- SupplierBioss
- Product NameSCNN1A Polyclonal Antibody
- Delivery Days Customer16
- ApplicationsFlow Cytometry, ImmunoFluorescence, Western Blot, ELISA, ImmunoCytoChemistry, ImmunoHistoChemistry, ImmunoHistoChemistry Frozen, ImmunoHistoChemistry Paraffin
- Applications SupplierWB(1:300-5000), ELISA(1:500-1000), FCM(1:20-100), IHC-P(1:200-400), IHC-F(1:100-500), IF(IHC-P)(1:50-200), IF(IHC-F)(1:50-200), IF(ICC)(1:50-200)
- CertificationResearch Use Only
- ClonalityPolyclonal
- Concentration1 ug/ul
- ConjugateUnconjugated
- Gene ID6337
- Target nameSCNN1A
- Target descriptionsodium channel epithelial 1 subunit alpha
- Target synonymsBESC2, ENaCa, ENaCalpha, LIDLS3, PHA1B1, SCNEA, SCNN1, epithelial sodium channel subunit alpha, ENaC subunit alpha, alpha ENaC-2, alpha-ENaC, alpha-NaCH, amiloride-sensitive epithelial sodium channel alpha subunit, amiloride-sensitive sodium channel subunit alpha 2, epithelial Na(+) channel subunit alpha, nasal epithelial sodium channel alpha subunit, nonvoltage-gated sodium channel 1 subunit alpha, sodium channel epithelial 1 alpha subunit, sodium channel, non voltage gated 1 alpha subunit, sodium channel, non-voltage-gated 1 alpha, sodium channel, nonvoltage-gated 1 alpha
- HostRabbit
- IsotypeIgG
- Protein IDP37088
- Protein NameEpithelial sodium channel subunit alpha
- ReactivityHuman, Mouse, Rat
- Storage Instruction-20°C
- UNSPSC41116161
References
- Bu Yang Huan Wu decoction prevents reperfusion injury following ischemic stroke in rats via inhibition of HIF-1 alpha, VEGF and promotion beta-ENaC expression. Chen ZZ et al., 2019 Jan 10, J EthnopharmacolRead this paper
- The E3 ubiquitin ligase Siah1 regulates adrenal gland organization and aldosterone secretion. Scortegagna M et al., 2017 Dec 7, JCI InsightRead this paper

![ENaC Alpha antibody [N3C2], Internal detects ENaC Alpha protein at cytoplasm by immunohistochemical analysis. Sample: Paraffin-embedded mouse kidney. ENaC Alpha stained by ENaC Alpha antibody [N3C2], Internal (GTX110436) diluted at 1:500. Antigen Retrieval: Citrate buffer, pH 6.0, 15 min](https://www.genetex.com/upload/website/prouct_img/normal/GTX110436/GTX110436_40863_20220617_IHC-P_M_22062121_206.webp)